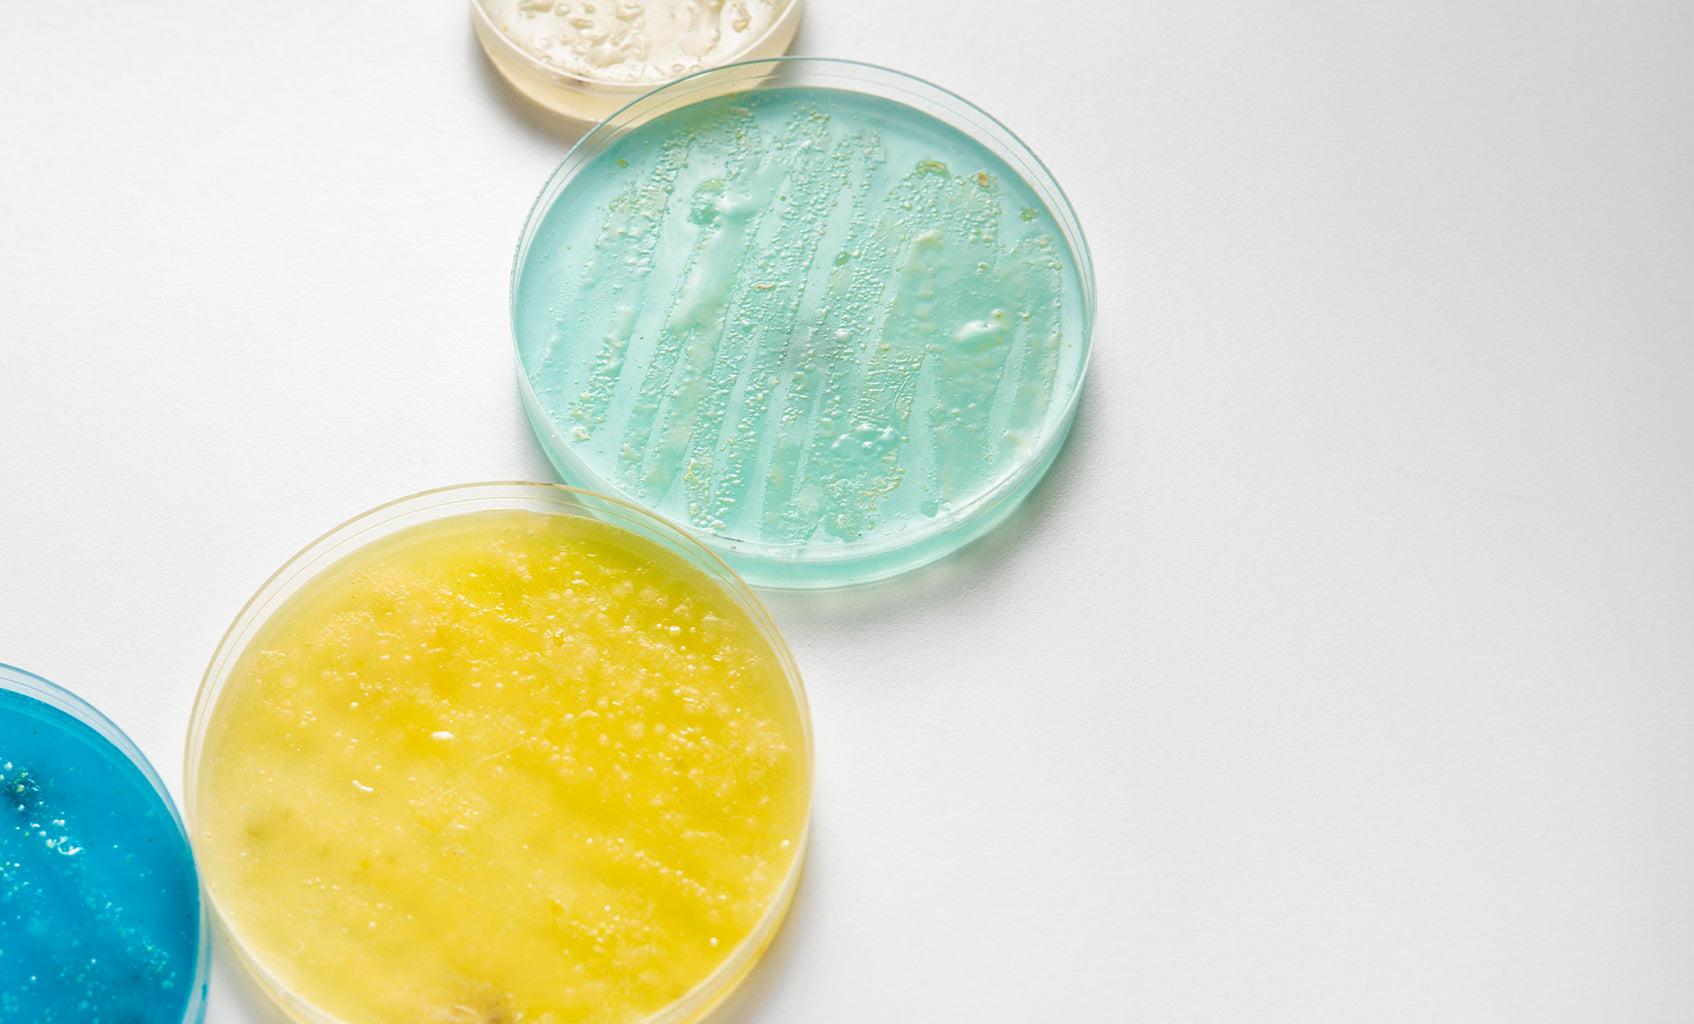

As a Doctor of Pharmacy (PharmD), I have experience across long-term care, insurance-based clinical services, and retail pharmacy. My work has focused on improving patient outcomes, ensuring care aligns with Medicare standards, and delivering high-quality, affordable healthcare services. I have provided direct patient care through immunizations, vaccinations, and medication counseling, with a consistent focus on patient-first care and clinical excellence. I am also the founder of PostGigs, a modern job platform that enables people and businesses to post opportunities and promote services directly, without middlemen, creating a more efficient and accessible way to connect work with workers.
...
GGrit Daily
Read Article

DDoctors Magazine
Read Article
ZZBIOME Health
Read Article

MMommy Rheum
Read Article
Dr. Katy Dubinsky, PharmD — Cofounder of PostGigs, a platform to post jobs or promote services without middlemen.